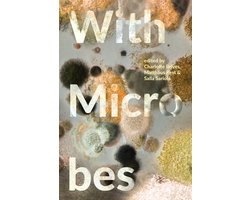
With Microbes

Geen afslanken voor de zomer meer. be2 mannen minder bezig met lichaamsvorm.
PDF versie | Print Versie | Html Versie
Auteur: be2 | Via Artikel Post
Gezien: 1823 |
Aantal woorden: 499 |
Datum: Tue, 19 Jul 2011 |
0 commentaar
Een nieuw be2 onderzoek onthult de houding van haar leden ten opzichte van lichaamsvormen en aantrekkelijkheid. be2, een van de grootste dating websites van Nederland, heeft onderzocht hoe mensen zich voorbereiden op de zomer; of ze trainen en of de lichaamsvormen van de potentiele partner belangrijk zijn. In het algemeen bleken de be2 klanten vrij onbevangen te zijn over deze onderwerpen:
Mannen doen meer hun best om in vorm te zijn voor de zomer:
71% van de vrouwen zegt dat ze geen speciale voorbereidingen doen (zoals dieeten of oefeningen doen) voor de zomer maanden. Terwijl bijna 60% van de mannen wel probeert om een gebalanceerd dieet te volgen of een paar oefeningen te doen voordat de zomer aanvangt.
Meeste mannen minder bezorgd over lichaamsvorm:
De meeste mannen en vrouwen denken dat uiterlijk niet de belangrijkste factor is als ze aan de partner van hun dromen denken. 57% van mannen en 63% van vrouwen geven aan dat uiterlijk niet de meest belangrijke factor is.
Zorgen over lichaamsvorm neemt af met leeftijd, behalve voor mannen boven de 55:
Het onderzoek bevestigt het feit dat mannen niet altijd minder oppervlakkig worden met de leeftijd. Integendeel, eenmaal boven de 55 zijn mannen geneigd om terug te vallen op de houding van hun jongere gelijke met 44% die op zoek is naar een vrouw met een ‘perfecte lichaam’ of ‘ronde vormen’ voor dating. Vrouwen, aan de andere kant, maken zich minder zorgen over het uiterlijk als ze volwassen worden. 73% van de dames over 55 geeft aan dat lichaamsvorm en uiterlijk onbelangrijk zijn.
Mannen minder bezorgd over gewichtstoename van geliefde:
36% van de mannen zegt dat ze het niet erg vinden als ze een partner hebben die veel is aangekomen. “Ik vind haar leuk zoals ze is ongeacht de tailleomvang.” Slechts 30% van de vrouwen voelt hetzelfde. De meerderheid van de ondervraagde mannen en vrouwen denkt dat ze zullen ingrijpen in zo’n situatie en zullen proberen om hun partner over te halen om af te vallen.
Jongere mensen meer relaxt over gewichtstoename van geliefde:
Waarschijnlijk is het verbazingwekkend dat juist de jongere mensen minder bezwaar hebben om een afspraakje met een online dating partner met overgewicht te maken. Meer dan 40% van jongeren onder de 35 vermeldt dat ze het niet erg vinden als hun partner in gewicht aankomt. Slechts 30% van de mensen boven de 35 vindt hetzelfde.
Over het onderzoek: Het onderzoek is uitgevoerd onder 6400 Europese respondenten tussen juli 2009 en juni 2011.
Over de Auteur
be2 is een van ‘s werelds grootste matchmaking service, bedoeld om echte soulmates bij elkaar te brengen, voor een ware lange liefde. Meer dan 20 miljoen leden in 37 landen geloven in be2’s methode, ontwikkeld door een team van psychologen, sociologen, en statitisten. Een succes percentage ven 40% geven hen gelijk!
Om meer over be2 en hun methode te weten, ga naar http://www.be2.nl
Press Office be2: press@be2.com
Gerelateerde artikelen
- deel dit artikel met anderen
Beoordeling: Nog niet beoordeeld
Login om te stemmen